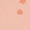
Orange Flower, variant on Gerber Baby Boys or Girls Casual Sleeveless Bodysuits, 5-Pack, Sizes 0/3 Months- 24 Months

Hero image 0 of Gerber Baby Neutral Onesies® Brand Cotton Rib Bodysuits, 5-Pack, 0 of 11
Best seller
Gerber Baby Neutral Onesies® Brand Cotton Rib Bodysuits, 5-Pack
Gerber Baby Neutral Onesies® Brand Cotton Rib Bodysuits, 5-PackGerber Baby Girl or Boy Gender Neutral Onesies Brand Cotton Rib Bodysuits 5 PackGerber Baby Girl or Boy Gender Neutral Onesies Brand Cotton Rib Bodysuits 5 PackGerber Baby Girl or Boy Gender Neutral Onesies Brand Cotton Rib Bodysuits 5 PackGerber Baby Girl or Boy Gender Neutral Onesies Brand Cotton Rib Bodysuits 5 PackGerber Baby Girl or Boy Gender Neutral Onesies Brand Cotton Rib Bodysuits 5 PackGerber Baby Girl or Boy Gender Neutral Onesies Brand Cotton Rib Bodysuits 5 PackGerber Baby Neutral Onesies Brand Cotton Rib Bodysuits 5 PackGerber Baby Girl or Boy Gender Neutral Onesies Brand Cotton Rib Bodysuits 5 PackGerber Baby Girl or Boy Gender Neutral Onesies Brand Cotton Rib Bodysuits 5 PackGerber Baby Girl or Boy Gender Neutral Onesies Brand Cotton Rib Bodysuits 5 PackGerber Baby Girl or Boy Gender Neutral Onesies Brand Cotton Rib Bodysuits 5 PackGerber Baby Girl or Boy Gender Neutral Onesies Brand Cotton Rib Bodysuits 5 PackGerber Baby Girl or Boy Gender Neutral Onesies Brand Cotton Rib Bodysuits 5 PackGerber Baby Girl or Boy Gender Neutral Onesies Brand Cotton Rib Bodysuits 5 PackGerber Baby Girl or Boy Gender Neutral Onesies Brand Cotton Rib Bodysuits 5 PackGerber Baby Girl or Boy Gender Neutral Onesies Brand Cotton Rib Bodysuits 5 PackGerber Baby Girl or Boy Gender Neutral Onesies Brand Cotton Rib Bodysuits 5 PackGerber Baby Girl or Boy Gender Neutral Onesies Brand Cotton Rib Bodysuits 5 PackGerber Baby Girl or Boy Gender Neutral Onesies Brand Cotton Rib Bodysuits 5 PackGerber Baby Girl or Boy Gender Neutral Onesies Brand Cotton Rib Bodysuits 5 PackGerber Baby Girl or Boy Gender Neutral Onesies Brand Cotton Rib Bodysuits 5 PackGerber Baby Neutral Onesies Brand Cotton Rib Bodysuits 5 PackGerber Baby Girl or Boy Gender Neutral Onesies Brand Cotton Rib Bodysuits 5 PackGerber Baby Girl or Boy Gender Neutral Onesies Brand Cotton Rib Bodysuits 5 PackGerber Baby Girl or Boy Gender Neutral Onesies Brand Cotton Rib Bodysuits 5 PackGerber Baby Neutral Onesies Brand Cotton Rib Bodysuits 5 PackGerber Baby Girl or Boy Gender Neutral Onesies Brand Cotton Rib Bodysuits 5 PackGerber Baby Girl or Boy Gender Neutral Onesies Brand Cotton Rib Bodysuits 5 PackGerber Baby Girl or Boy Gender Neutral Onesies Brand Cotton Rib Bodysuits 5 PackGerber Baby Girl or Boy Gender Neutral Onesies Brand Cotton Rib Bodysuits 5 PackGerber Baby Girl or Boy Gender Neutral Onesies Brand Cotton Rib Bodysuits 5 PackGerber Baby Girl or Boy Gender Neutral Onesies Brand Cotton Rib Bodysuits 5 PackGerber Baby Girl or Boy Gender Neutral Onesies Brand Cotton Rib Bodysuits 5 PackGerber Baby Neutral Onesies Brand Cotton Rib Bodysuits 5 PackGerber Baby Girl or Boy Gender Neutral Onesies Brand Cotton Rib Bodysuits 5 PackGerber Baby Girl or Boy Gender Neutral Onesies Brand Cotton Rib Bodysuits 5 PackGerber Baby Girl or Boy Gender Neutral Onesies Brand Cotton Rib Bodysuits 5 PackGerber Baby Girl or Boy Gender Neutral Onesies Brand Cotton Rib Bodysuits 5 PackGerber Baby Girl or Boy Gender Neutral Onesies Brand Cotton Rib Bodysuits 5 PackGerber Baby Girl or Boy Gender Neutral Onesies Brand Cotton Rib Bodysuits 5 PackGerber Baby Girl or Boy Gender Neutral Onesies Brand Cotton Rib Bodysuits 5 PackGerber Baby Girl or Boy Gender Neutral Onesies Brand Cotton Rib Bodysuits 5 Pack
Actual Color:GREY HEATHER
Black, $19.99
$4.00/ea
selected, GREY HEATHER, $16.99
$3.40/ea
Gray
Pink, $16.99
$3.40/ea
Red, $19.99
$4.00/ea
White, $15.99
$3.20/ea
WHITE, $15.99
$3.20/ea
RED, $19.99
$4.00/ea
PINK, $16.99
$3.40/ea
BLACK, $19.99
$4.00/ea
Blue, $13.99, was $16.99, Out of stock
$16.99$2.80/ea
Clothing Size:6-9 Months
Current price is USD$16.99$3.40/ea
Price when purchased online
- Free 90-day returns
How do you want your item?
Try 30 days of Free Shipping with Walmart+! Choose plan at checkout.
Columbus, 43215
Arrives by Sat, Jan 31
.Order within 13 hr 21 min
Sold by Gerber Childrenswear
Fulfilled by Walmart
4.783870967741936 stars out of 5, based on 931 seller reviews(4.8)
Free 90-day returns
About this item
Customer ratings & reviews
4.8 out of 5 stars
How item rating is calculated
Reviews summary
Pros
- : Fits as expected with comfortable soft material.
- : Made of durable and soft material.
- : Available in various vibrant and soft shades.
- : Fabric is cotton-based and gentle to the touch.
- : Offers great value at this cost.
- : Made of a flexible textile material.
Generated by AI
Customer images
Sort by |
Showing 1-3 of 589 reviews
Nov 11, 2025
Linda R.
5 out of 5 stars review
Stress free
Incentivized Review
Review from http://gerberchildrenswear.com
Helpful?
Apr 14, 2025
Taylor
Item details
Color: Red
Clothing size: 6-9 Months
5 out of 5 stars review
Verified Purchase
Helpful?
Apr 15, 2025
Eszter P.
5 out of 5 stars review
I love these onsies. I
Incentivized Review
Review from http://gerberchildrenswear.com
Helpful?